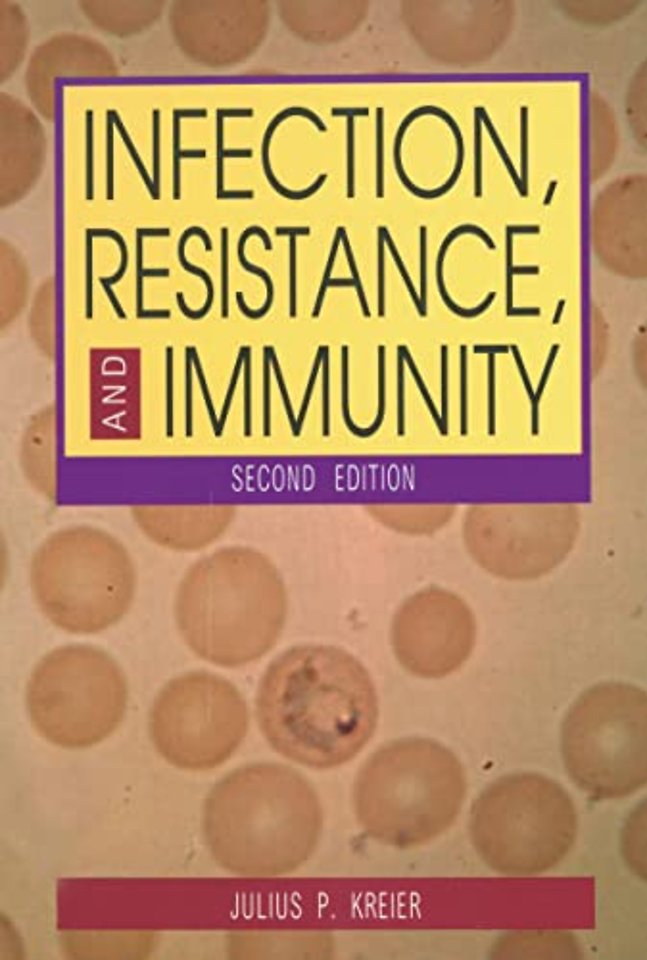
Infection, Resistance, and Immunity, Second Edition

Infection, Resistance, and Immunity, Second Edition
Samenvatting
Designed as an introductory textbook, Infection, Resistance and Immunity provides basic information on the workings of the immunological system and on infectious processes and their control. With sections on immunological disorders, immunization, immunodiagnosis, and epidemiology, it relates immunology to practical problems in medicine. The book includes a section on comparative immunology, introducing students to differences among immunological systems among common species of nonhuman animals. Written for the advanced undergraduate, the focus is on host-parasite interactions—distinguishing this text from other standard texts, which focus on the cellular mechanisms of the immune response.